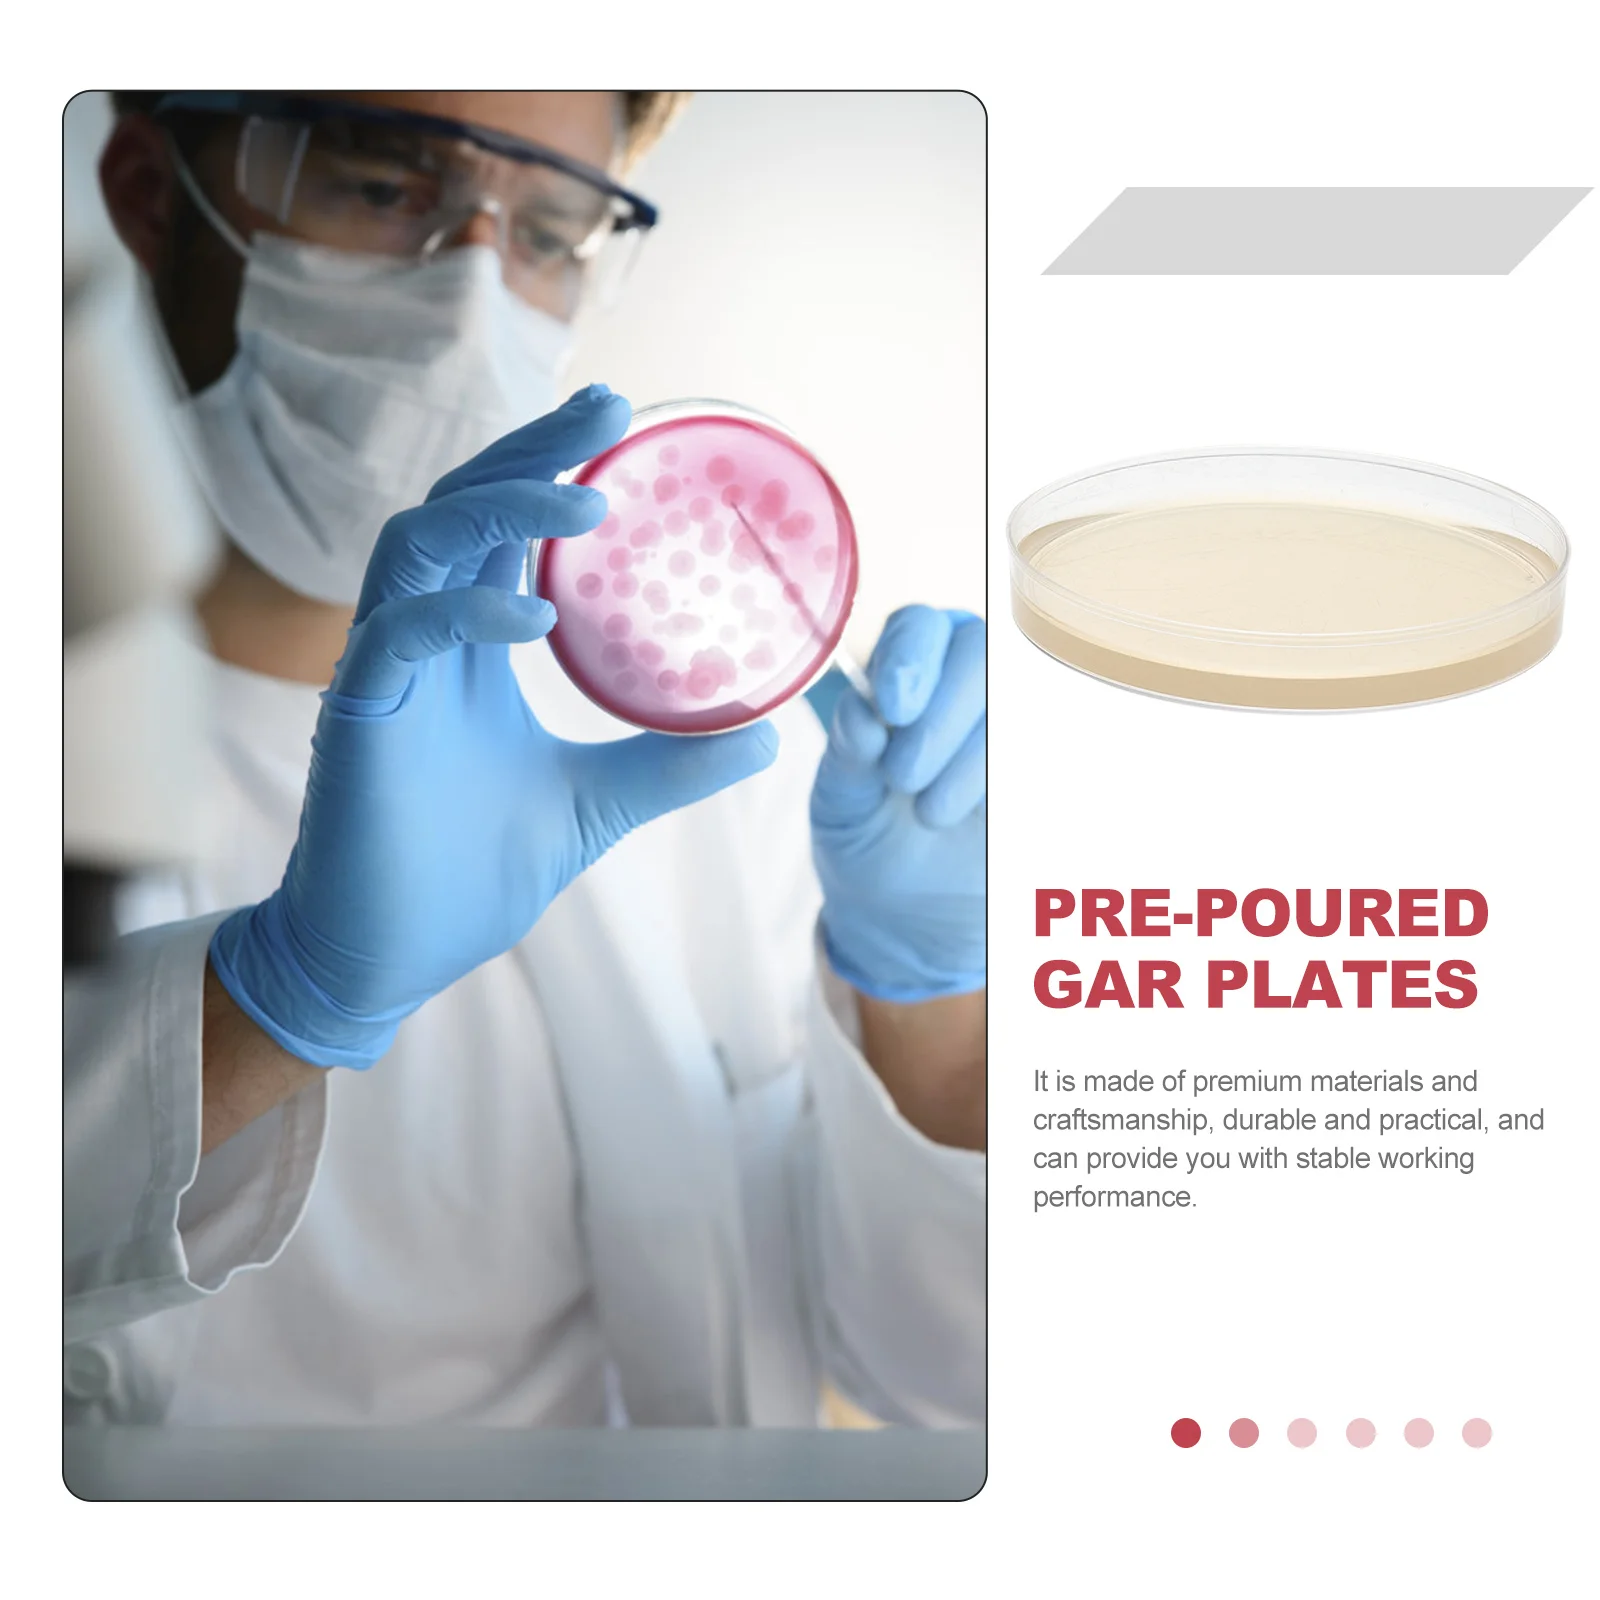

10 шт. чашки Петри с крышками, Прозрачная чаша Петри, образовательный проект по научной ярмарке STEM для школьных лабораторий, научных проектов
График изменения цены & курс обмена валют
Пользователи также просматривали

$5.45
Лесная тематика милые цветочные серьги-гвоздики для женщин и девочек простые красивые летние новые стильные серьги-гвоздики для вечеринки свидания подарок
joom.com
$61.13
Сладости для взрослых 12 видов ассорти набор 7 видов семян хурмы 5 видов макаронных изделий кондитерские изделия Abe Sachi
joom.com
$10.18
Jiami Le Baby Girl Princess Shoes, Soft-Sole, Non-Slip, Indoor, Spring/Autumn 11cm/63g
joom.com
$24.30
Мужская обувь Дышащие маленькие белые туфли Мужские студенческие модные спортивные туфли на платформе Повседневная обувь Кроссовки Модная обувь 39
joom.com
$5.39
Эластичный обруч для волос, расширенный дизайн, легкая повязка на голову, противоскользящие зубцы, корейский стиль, гибкая повязка для волос, аксессуар для волос вино красного
joom.com
$23.63
Утягивающие джинсовые шорты для женщин 2025 года, летняя мода, длина три четверти, сексуальные облегающие джинсы, узкие однотонные джинсовые шорты S синий
joom.com
$6.10
Кровать с рисунком сердца для дома, гостиной, автомобиля, офиса, дивана, наволочки, чехлы для подушек 40x40cm
joom.com
$27.31
Для Honda CBR 600RR CBR600RR CBR 600RR 2004-2022 2021 2020 2019 Мотоциклетные аксессуары с ЧПУ Подставка Винт M8 Маятниковые катушки Слайдер серебряный
joom.com
$23.68
7inch Record MASANORI KOIDE - Futari FLS1027PROMO FOR LIFE 1978 Japan Japanese Enka Used
joom.com
$56.13
Чехол для клюшки для гольфа LeFeng 460 куб. см. Идеально подходит для драйвера и фервея. Деревянный интересный чехол для клюшки в форме ладони. (Бесконечная ладонь, водитель)
joom.com
$23.68
Половинки тапочек летние парусиновые маленькие белые туфли женские студенческие плоские корейские туфли с одной педалью ленивые туфли женские беременные женщины без каблука 35
joom.com
$90.08
50pcs Invitations Glitter Paper Invitation Card with RSVP Greeting Cards Gift Card for Wedding Birthday Quinceanera Party Decor
aliexpress.com
$3.82
30ml Glove Glue Goalkeeper Antislip Grip Boost For Football Gloves Latex Goalkeeper Gloves Enhance Sticky Viscosity Tackifier
aliexpress.com
$17.95
hsa summer tie-dye print women sleeve o-neck short camouflage femme t-shirt mujer sweetshirts 210417, White
dhgate.com
$26.32
mens casual shirts summer solid linen set polo neck lace short sleeve 230718, White;black
dhgate.com
$97.54
amarillo rare ot stitched gorillas nascar night hockey jersey mens kids throwback jerseys, Black
dhgate.com
$50.47
fashion designer bags small women 2022 new c-rocodile pattern women's versatile crossbody handbags clutch bags for women
dhgate.com
$87.59
spring summer pleated dresses famale printed loose oversize plus size dress round collar yj310 210507, Black;gray
dhgate.com
$15.93
coromose winter men long johns mens thermal underwear sets plus velvet warm long john oneck thermal undershirts trousers l3xl4401886, Black;brown
dhgate.com
$30.78
50% off wholesale of sunglasses new anti blue light decorative no degree glasses flat mirror 0221, White;black
dhgate.com
$227.09
fully iced out vvs moissanite diamond cuban bracelet hip hop rapper cuban link chain, Silver
dhgate.com
$30.60
11 jumpman 11s basketball shoes animal instinct citrus sports sneakers concord jubilee 25th anniversary mens w og designer shoes, Black
dhgate.com
$131.68
Mens Designer Ski Goggles For Women Cycling Sunglasses Mens Luxury Hot Large Factory Eyewear Glasses With Magnetic Fashion Cool UV400 Protect Lens Z1573 Z1744
dhgate.com
$24.77
classic men's t-shirts high street rhude simple letter printing loose and versatile cotton short sleeve t-shirt, White;black
dhgate.com
$94.30
Projectors S30 Gloal 400 ANSI Lumens LED 4K Portable Projector Android 1080P HD Home HDMI Theater Mini 10 Movie Proyectors W0419
dhgate.com
$21.71
designer bucket trucker baseball hat new european american street color contrast duck tongue spring summer letter embroidery curved brim cap, Blue;gray
dhgate.com
$24.37
Z-образный Зажим RC самолет плоскогубцы для гибки рулевой тяги щипцы для щипцов для Сервопривод направление дроссельной
banggood.com
$44.78
2X DS5160 SSG 60 кг 8,4 в высоковольтный водонепроницаемый цифровой сервопривод для 1:5 Радиоуправляемый автомобиль SAVOX-0236 LOSI XL 5T Robot Arm 270 сервопривод
aliexpress.ru
$4.01
Новинка 2021, маленькие строительные блоки Pokemon, маленькие Мультяшные модели животных Picachu, развивающая игра, графические блоки, игрушки Pokemon
aliexpress.ru
$26.66
5.0-Ear Contact True Wireless Stereo Headset with USB Charging, Ultra Long Battery Life, Waterproof Sports Bluetooth Headset
aliexpress.com
$19.66
Fashion Anime Dragon Ball Z Hoodies 2 piece suit Men Sweatshirts mens suits with pants Goku Hooded Cartoon Hoody clothing Sets
aliexpress.com